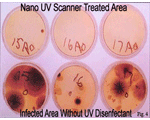
Killing Surface Germs with UV Helps Prevent the Spread of Disease, Viruses, Bacteria

Killing Surface Germs with UV Helps Prevent the Spread of Disease, Viruses, Bacteria
Disinfecting the surfaces we are exposed to is the key to preventing the spread of germs, viruses and bacteria. As with the photo on the right, the top displays the bacteria treated area and the bottom shows untreated. Bacteria can be harmful and even fatal to our health. But with all of the products on and in the market that advertise disinfection, there is a much more effective solution – the use of a Ultraviolet (UV) Light in a portable device called the Nano UV Disinfection Scanner. While there are still a large selection of antibacterial sprays that promise to protect and disinfect, you cannot use them on electronic surfaces due to the danger of getting those surfaces wet. All it takes is 10 seconds with the UV Light to destroy germs and bacteria and this revolutionary UV technology is a FDA registered concept, as compact in size as a cell phone, and very inexpensive. Protecting your family by disinfecting of the surfaces you come into contact with has never been more effective and time saving, wherever you may be.
